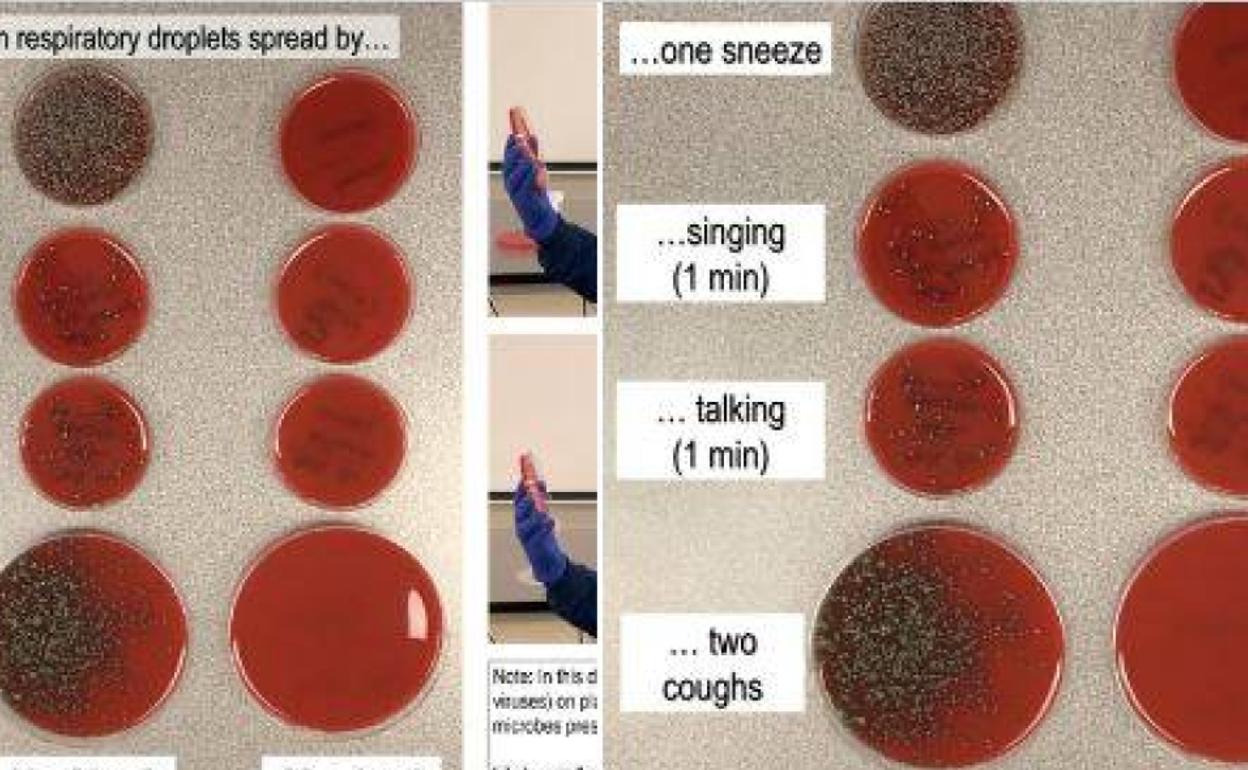

Secciones
Servicios
Destacamos
Gijón
Necesitas ser suscriptor para acceder a esta funcionalidad.
Domingo, 28 de junio 2020, 10:29
Necesitas ser suscriptor para acceder a esta funcionalidad.
Compartir
Rich Davis es microbiólogo del Hospital Providence Sacred Heart de Spokane en Washington, EEUU. Ha utilizado su cuenta en Twitter para demostrar la importancia de usar la mascarilla contra el coronavirus a través de un simple pero efectivo experimento.
Davis estornudó, cantó, habló y tosió dos veces sin mascarilla sobre varias placas de cultivo y después repitió los pasos con la mascarilla puesta sobre placas de cultivo diferentes.
Tras varios días comprobó el resultado, que es revelador. Observó las placas sobra las que había realizado los pasos con y sin mascarilla, comprobando claramente a través de las «colonias de bacterias» donde «habían aterrizado las gotas» de saliva. «La mascarilla bloquea la mayoría de ellas», explicó el microbiólogo.
What does a mask do? Blocks respiratory droplets coming from your mouth and throat.
Rich Davis, PhD, D(ABMM), MLS 🦠🔬🧫 (@richdavisphd) June 26, 2020
Two simple demos:
First, I sneezed, sang, talked & coughed toward an agar culture plate with or without a mask. Bacteria colonies show where droplets landed. A mask blocks virtually all of them. pic.twitter.com/ETUD9DFmgU
Davis comprobó también la importancia de la distancia social y tosió a una distancia de metro y medio y de dos metros. El resultado, también evidente: a mayor distancia, menos gotas llegan desde la boca a las placas de cultivo.
What about keeping your distance?
Rich Davis, PhD, D(ABMM), MLS 🦠🔬🧫 (@richdavisphd) June 26, 2020
Second demo: I set open bacteria culture plates 2, 4 and 6 feet away and coughed (hard) for ~15s. I repeated this without a mask.
As seen by number of bacteria colonies, droplets mostly landed <6 ft, but a mask blocked nearly all of them. pic.twitter.com/8wDdvIHHMa
Noticia Relacionada
Publicidad
Publicidad
Te puede interesar
Publicidad
Publicidad
Reporta un error en esta noticia
Comentar es una ventaja exclusiva para suscriptores
¿Ya eres suscriptor?
Inicia sesiónNecesitas ser suscriptor para poder votar.